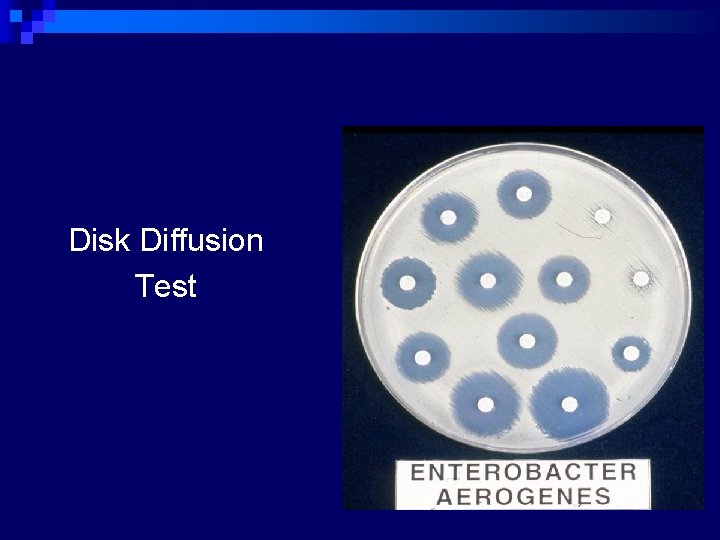
Disk Diffusion Test
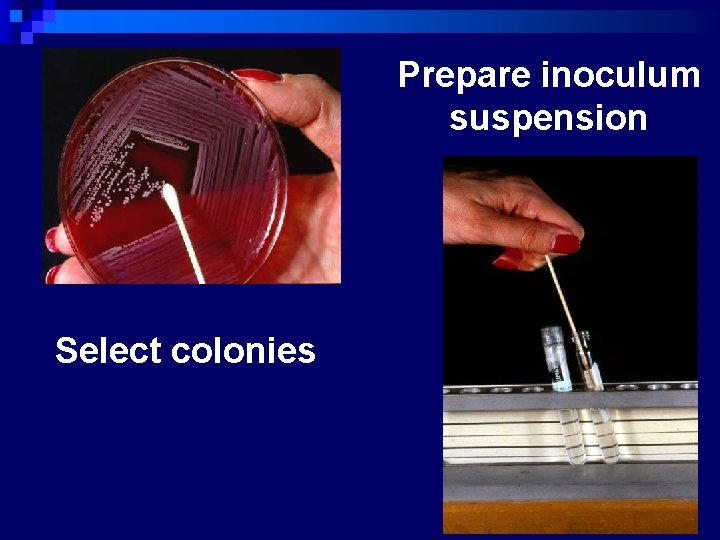
Prepare inoculum suspension Select colonies

Mechanism of Antimicrobial Resistance Dr Nisha Goyal Lecturer

Mechanism of Antimicrobial Resistance Dr. Nisha Goyal Lecturer Department of Microbiology

ANTIMICROBIAL RESISTANCE n Refers to development of resistance to an antimicrobial agent by a microorganism n Can be of two types¨ Intrinsic ¨ Acquired

Intrinsic Resistance n Refers to innate ability of bacterium to resist a class of antimicrobial agents due to its inherent structural or functional characteristics n E. g. vancomycin resistance among gram -negative bacteria and metronidazole resistance among aerobic bacteria

Acquired Resistance n Emergence of resistance in bacteria that are ordinarily susceptible to antimicrobial agents n By acquiring the genes coding for resistance n Most prevalent form of antimicrobial resistance shown by bacteria

Mutational and Transferable Drug Resistance Bacteria acquire new genes mainly by two broad methods: n Mutational Resistance n Transferrable Drug Resistance

Mutational Resistance n Resistance develops due to mutation of resident genes. n Usually, a low level resistance n Develops to one drug at a time; can be overcome by combination of different classes of drugs n Typically seen in Mycobacterium tuberculosis (reason for multidrug therapy using 4 -5 different

Transferrable Drug Resistance n Plasmid coded, Horizontal spread; usually transferred by conjugation or rarely by transduction, or transformation n Resistance coded plasmid (R plasmid) can carry multiple genes, each coding for resistance to one class of antibiotic n High degree of resistance to multiple drugs, which cannot be overcome by using combination of drugs

n Susceptibility test, main purposes: ¨ As a guide for treatment n Sensitivity of a given m. o. to known conc. of drugs n Its concentration in body fluids or tissues ¨ As an epidemiological tool n The emergence of resistant strains of major pathogens n Continued surveillance of the susceptibility pattern of the prevalent strains

Antimicrobial Susceptibility Testing n Dilution method ¨ vary amount of antimicrobial substances incorporated into liquid or solid media ¨ followed by inoculation of test bacteria n Diffusion method ¨ Put a filter disc, or a porous cup/a bottomless cylinder containing measured quantity of drugs on the a solid medium that has been seeded with test bacteria

Conventional testing methods n Disc-diffusion method: ¨ Principle – impregnated disc absorbs moisture from the agar and antibiotic diffuses into the agar medium ¨ As distance from disc increases, antibiotic concentration decreases ¨ Visible growth of bacteria occurs on the surface of agar where the concentration of antibiotic falls below the inhibitory level for the test strain. ¨ Concentration of diffused antibiotic at the interface of growing and inhibited bacteria approximates to the MIC obtained in dilution tests.

Disc Diffusion Method

Antibiotic discs – ¨ commercially prepared discs 6 mm in diameter are used ¨ Can be prepared from Whatman filter paper no. 1, sterilized in hot air oven ¨ Antibiotics delivered with 20 gauge wire loop, diameter 2 mm. This delivers 0. 005 ml antibiotic to each disc ¨ Discs and disc dispensers should be stored in sealed containers with a dessicant ¨ Bulk stock kept at -20 o. C ¨ Working stock kept in sealed containers with dessicant , stored at less than 8 o. C

n Turbidity standard for inoculum preparation – ¨ To standardize the inoculum density ¨ Ba. SO 4 turbidity standard, equivalent to 0. 5 Mc. Farland is used ¨ Prepared by 0. 5 ml 0. 048 mol/L Ba. Cl 2 + 99. 5 ml 0. 18 mol/L H 2 SO 4 ¨ Density verified by using spectrophotometer ¨ Absorbance at 625 nm should be 0. 008 – 0. 10 for 0. 5 Mc. Farland standard ¨ Densities verified monthly

Disc Diffusion Method n Procedure (Modified Kirby-Bauer method: National Committee for Clinical Laboratory Standards. NCCLS) ¨ Prepare applx. 108 CFU/ml bacterial inoculum in a saline or tryptic soy broth tube (TSB) or Mueller-Hinton broth (5 ml( Pick 3 -5 isolated colonies from plate n Adjust the turbidity to the same as the Mc. Farland No. 0. 5 standard. ¨ Streak the swab on the surface of the Mueller-Hinton agar (3 times in 3 quadrants( ¨ Leave 5 -10 min to dry the surface of agar n

Disc Diffusion Method n Procedure (cont. ) ¨ Place the appropriate drugimpregnated disc on the surface of the inoculated agar plate ¨ Invert the plates and incubate them at 35 o. C, o/n (18 -24 h) ¨ Measure the diameters inhibition zone in mm of Bacterial growth
Disk Diffusion Test
Prepare inoculum suspension Select colonies

Mix well Standardize inoculum suspension

Swab plate Remove sample

Incubate overnight Add disks Measure Zones

Disk Diffusion Test n Qualitative results ¨ Susceptible ¨ Intermediate – may respond if infection is at body site where drug concentrates (e. g. urine) or if higher than normal dose can be safely given ¨ Resistant

Two types of disc diffusion methods: 1) Kirby –Bauer (recommended by the CLSI and WHO) 1) Same plate comparative disc diffusion test (Stokes) ( used in British laboratories)

Kirby-Bauer method ¨ Sterile cotton swab dipped in the adjusted suspension ¨ MH agar plate inoculated by streaking the swab over the entire agar surface ¨ Predetermined battery of antimicrobial discs are dispensed ¨ Discs distributed evenly so that they are no closer than 24 mm from center to center ¨ 12 discs should be placed on one 150 mm plate or 5 discs on 100 mm plate ¨ Once in contact with the agar surface the disc should not be relocated. Plates incubated in ambient air

Stokes method o Tests of organism of unknown sensitivity and control organism of known sensitivity are set up at the same time and in identical conditions on the same plate o The control inoculum are spread in two bands on either side of the plate, and the test organism is inoculated onto the central area of the plate o An uninoculated gap 2 -3 mm wide should separate the test and control areas o Interpretation done by comparing the size of inhibition zone

Factors Affecting Size of Zone of Inhibition n Inoculum density Larger zones with light inoculum and vice versa n Timing of disc application If after application of disc, the plate is kept for longer time at room temperature, small zones may form n Temperature of incubation Larger zones are seen with temperatures < 35 o. C n Incubation time Ideal 16 -18 hours; less time does not give reliable results n Potency of antibiotic discs Deterioration in contents leads to reduced size n Composition of medium Affects rate of growth, diffusion of antibiotics and activity of antibiotics

Factors Affecting Size of Zone of Inhibition n Acidic p. H of medium Tetracycline, novobiocin, methicillin zones are larger n Alkaline p. H of medium Aminoglycosides, erythromycin zones are larger n Reading of zones Subjective errors in determining the clear edge n Size of the plate Smaller plates accommodate less number of discs n Depth of the agar medium (4 mm) Thin media yield excessively large inhibition zones and vice versa n Proper spacing of the discs (2. 5 cm) Avoids overlapping of zones

Modify methods for fastidious bacteria Media recommended for test of fastidious bacteria


THANK YOU
- Slides: 29